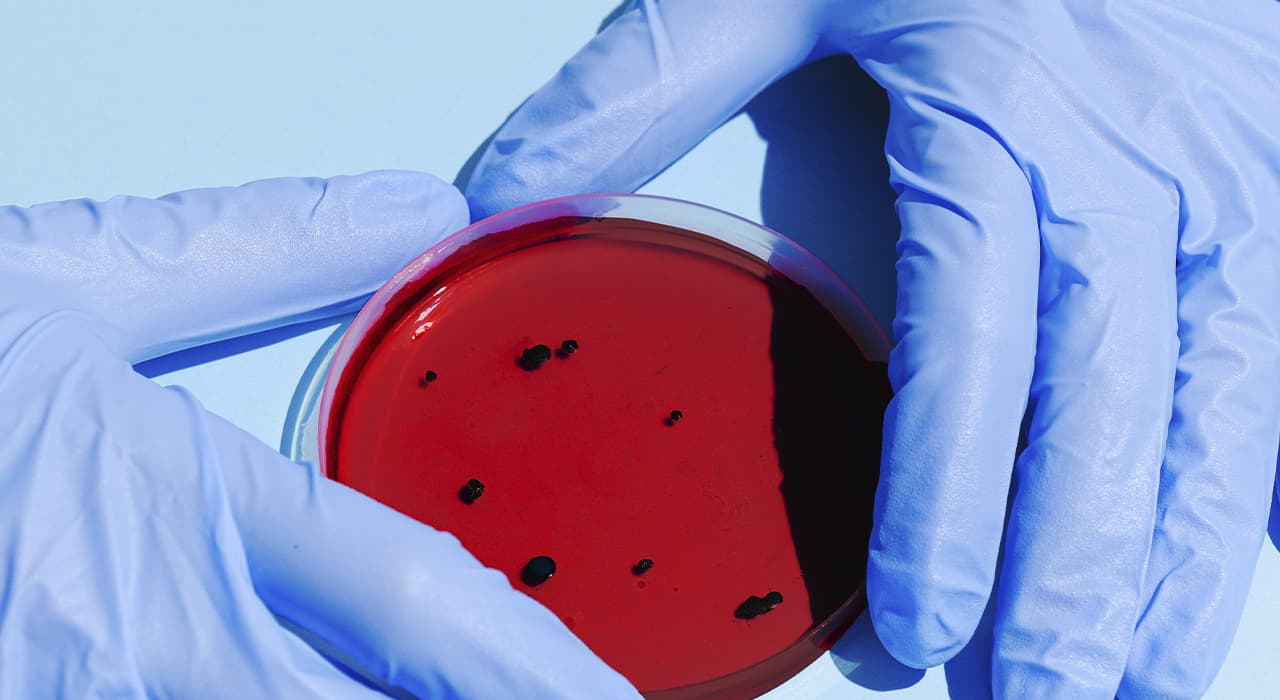

To date, at least eight countries in the WHO European Region – Belgium, France, Germany, Italy, Portugal, Spain, Sweden and the United Kingdom – have reported cases of monkeypox in recent days. Outside the countries where monkeypox is considered endemic, cases have also recently been reported in Australia, Canada and the United States.
Monkeypox is a rare viral disease that usually occurs in the forested areas of Central and West Africa, which are home to animals that carry the virus.
The WHO said in a statement that so far about 80 cases of infection have been confirmed in 11 countries worldwide, with another 50 cases being studied.
“As we enter the summer season in the European region with mass gatherings, festivals and parties, I am concerned that there will be more cases of infection…,” said WHO European Regional Director Hans Kluge.
Monkeypox is transmitted by direct human-to-human contact, including sexual contact, or by contact with contaminated materials.
Monkeypox is a usually self-healing disease with symptoms lasting 14 to 21 days. The infection usually causes mild symptoms, with itching or pain in the affected areas on the skin; in some cases, the infection may be more severe.
The number of cases in the region is relatively low at this point, but the fact that some of the cases do not appear to involve travel to countries where monkeypox is endemic is a cause for concern.
Many cases are detected in clinics specializing in sexually transmitted infections. At this point, it is unclear how widely the virus is circulating in the population, but an increase in cases should be expected in the coming days.
The WHO said people with suspected illness should be tested and isolated.
WHO is working closely with countries in the region, sharing information and supporting the detection and investigation of cases.
WHO says it is monitoring the rapidly evolving situation and will publish updates on it.